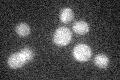
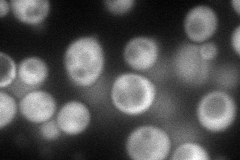
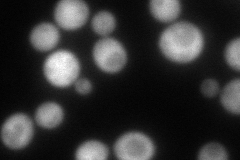
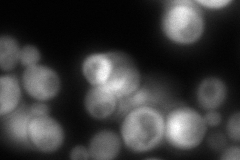

View description
Transcriptional coactivator that bridges the DNA-binding region of Gcn4p and TATA-binding protein Spt15p; suppressor of frameshift mutations
Localization:
Intensity:
Fold change:
Significance:
-
C’ GFP library in SD
below threshold18.13 -
N' NOP1pr-GFP in SD
cytosol118.451 -
N' TEF2pr-mCherry in SD
below threshold0 -
N' NATIVEpr-GFP in SD
cytosol245.265 -
N' TEF2pr-VC and Cyto-VN in SD

cytosol58.8834 -
C’ GFP library in SD+DTT

cytosol15.330.84No -
C’ GFP library in SD+H2O2

cytosol15.590.86No -
C’ GFP library in Starvation Media

cytosol15.250.84No -
C’ GFP library on the background of Pup2-DaMP

below threshold -
C’ GFP library on the background of CCT mutant

below threshold15.68040.86467No
